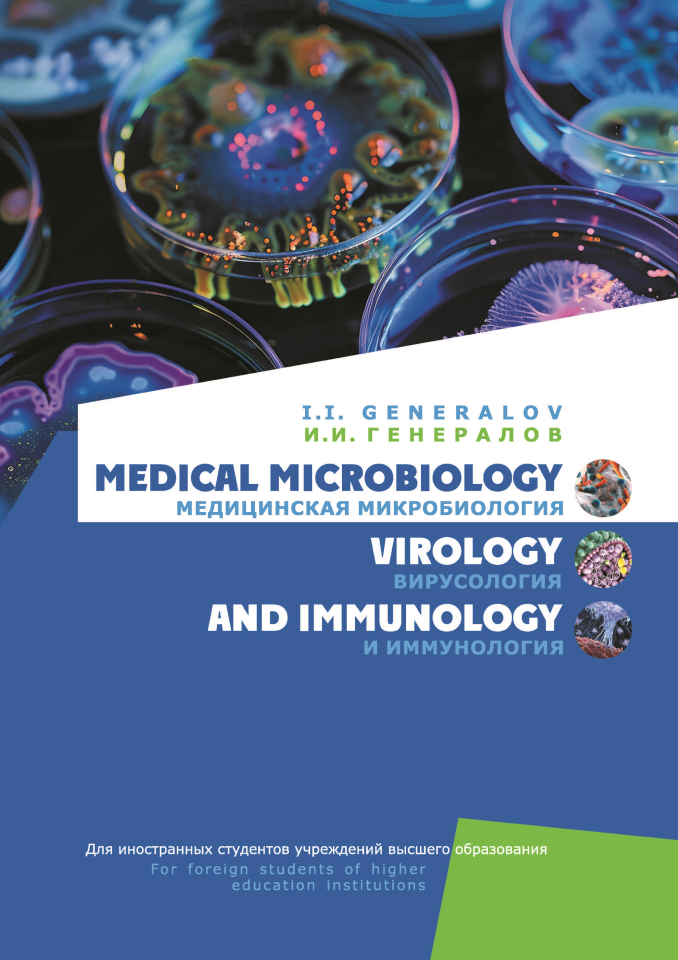
Medical microbiology. Медицинская микробиология

Технология строительного производства. В 2 частях. Часть 2
В. Н. Черноиван, С. Н. Леонович, Н. В. Черноиван

Героі Беларусі. Кніга пра людзей, ганараваных званнем «Герой Беларусі» (Серыя «Я ганаруся!»)…
Д. І. Радзькоўская

Партрэты беларускіх пісьменнікаў на ўроках літаратурнага чытання ў пачатковай школе…
Г. М. Федаровіч, Э. У. Сапожнікава

Технология строительного производства. В 2 частях. Часть 1.
В. Н. Черноиван, С. Н. Леонович, Н. В. Черноиван

Топливные и функциональные материалы ядерных энергетических установок
И. И. Чернов, М. С. Стальцов, А. В. Тенишев, В. В. Углов, Н. Н. Черенда

Чалавек і свет. Мая Радзіма – Беларусь. Практыкум. 4 клас
I. В. Прошчанка, Ю. С. Шыпiкава, М. Р. Ясюкевiч

Конструкционные материалы активных зон ядерных энергетических установок
И. И. Чернов, М. С. Стальцов, А. В. Тенишев и др.

Немецкий язык. 5-9 классы. Дидактические и диагностические материалы: Пособие для учителей. Серия «Учимся мыслить и действовать»…
И. В. Чепик, Е. В. Зуевская, И. В. Пасютина

Испанский язык. 3-4 классы. Дидактические и диагностические материалы. Пособие для учителей. (Серия «Учимся учиться»)…
Т. Э. Цыбулева, О. В. Янукенас

Испанский язык. 3-4 классы. Дидактические и диагностические материалы. Пособие для учащихся. (Серия «Учимся учиться»)…
Т. Э. Цыбулева, О. В. Янукенас
СКОРО В ПРОДАЖЕ
НОВОСТИ
Прэзентацыя тэматычнага нумара “Беларускага гістарычнага часопіса”
12-12-2025 Новости
 Читать полностью
Читать полностью Караткевіцкі тыдзень “Роднага слова”: панарама навуковых і прэзентацыйных падзей…
02-12-2025 Новости
 Читать полностью
Читать полностью «Беларускі гістарычны часопіс» на хвалях Першага нацыянальнага канала Беларускага радые…
18-11-2025 Новости
 Читать полностью
Читать полностью Торжественное награждение сотрудников издательства «Адукацыя і выхаванне» ко Дню учителя…
06-10-2025 Новости
 Читать полностью
Читать полностью Министерство образования разработало и утвердило инструктивно-методическое письмо по организации социальной, воспитательной и идеологической работы в…
06-08-2025 Новости
 Читать полностью
Читать полностью Государственное предприятие «Издательство «Адукацыя і выхаванне» поздравляет с Днём Независимости Республики Беларусь…
03-07-2025 Новости
 Читать полностью
Читать полностью Издательство «Адукацыя і выхаванне» на фестивале «МАЛАДЗЕЧНА – 2025»
17-06-2025 Новости
 Читать полностью
Читать полностью 26 мая к Международному дню защиты детей начнёт работу общественная приёмная
26-05-2025 Новости
 Читать полностью
Читать полностью Падведзены вынікі конкурсу мастацкіх перакладаў з кітайскай мовы “Люстэрка слоў”…
17-04-2025 Новости
 Читать полностью
Читать полностью